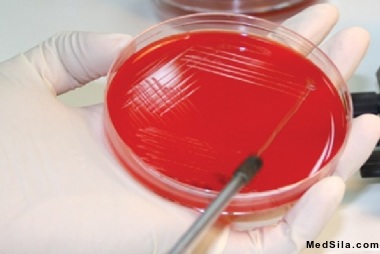
no alt var

Общие сведения
Лабораторный метод анализа мочи, при котором оценивают функциональные возможности мочевыделительной системы. Анализ мочи включает в себе оценку физико-химические свойства мочи, микробиологические и биохимические показатели. А также дает возможность фельдшеру-лаборанту проанализировать осадок мочи и дать полноценное заключение.
Следует напомнить, что моча является биоматериалом, который появляется путем фильтрации плазмы крови в капиллярных клубочках и обратного всасывания, затем происходит реабсорбция.

Как же правильно сдавать анализ мочи?
Сбор материала зависит от вида анализа, но есть общие правила. Такие как сбор мочи производят после тщательного туалета половых органов, в утренние часы, в сухую, чистую иногда в стерильную посуду (чаще всего пациенты приобретают специальные контейнеры в аптечных киосках).

Основные показатели
Количество мочи:
Запах мочи:
Запах мочи может быть весьма разнообразным. При некоторых заболеваниях запах является как отличительной чертой. Запах ацетона при сахарном диабете, запах аммиака-цистит, запах гнилой рыбы-при генетических заболеваниях, при накоплении триметиламина. Цвет мочи:
Привычный цвет-соломенно-желтый. Но при патологии цвет меняется, например, при гломерулонефрите.
Прозрачность мочи:
Прозрачность меняется в зависимости от наличие «примесей» или клеточных элементов, солей в мочи. При добавлении щелочей в осадок выпадают ураты, при взаимодействии уксусной кислоты-фосфаты, тогда прозрачность мочи «восстанавливается».
Белок в моче
В минимальном количестве присутствует в моче, но лабораторными методами его не определить. Поэтому принято считать, что в норме белка нет. При значительных количествах белок не только определяется, но является еще и признаком патологии (гломерулонефрит, гестоз, амилоидоз почек). Сахар, кетоновые тела в моче являются показателями патологии и выявляются при сахарном диабете, голодании, кетоацидозе.
Виды анализа мочи
-
Общий анализ мочи Самый распространенный, быстрый анализ с которым каждый столкнулся в своей жизни. Позволяет оценит работу мочевыделительной системы, позволяет заподозрить патологии и продолжить диагностику заболеваний почек, но уже другим методом. В ОАМ (общий анализ мочи) оценивают физико-химические свойства мочи (цвет, мутность, реакцию, относительную плотность; наличие белка, сахара, кетоновых тел), а также произвести микроскопию осадка мочи (эпителий и его вид, эритроциты, лейкоциты, соли, цилиндры; а также наличие бактерий, грибов).
-
Анализ мочи по Нечипоренко Анализ позволяет оценить функциональное состояние мочевыделительного тракта в 1 мл мочи. В результате обнаруживаются эритроциты (как признак нормы), лейкоциты (тоже как признак нормы), цилиндры (признак патологии).

- Анализ мочи по Зимницкому Оценивается концентрационная функция почек (измеряют плотность мочи, объем, концентрацию аммиака, солей, белков).
Анализ показывает соотношение ночного и дневного диуреза (мочеиспускание); назначают при патологии почек, сердечно-сосудистой системы.
- Трехстаканная проба, при которой одно мочеиспускание делят на три порции для оценки каждого отдела мочеиспускания в отдельности.
- Бактериологические методы исследования мочи, позволяют оценить степень стерильности уретры (оценка количества микроорганизмов, вид, степень обсеменения, плюс оценка проводимой бактериальной терапии).
-
Так же существует методы исследования мочи, которые в современной диагностике уже немного забыты. Например, метод по Каковскому-Аддису (определяют наличие и количество форменных элементов в моче). Метод весьма трудоемкий и дорогой, поэтому потерял актуальность. Проба Сулковича (определяют концентрацию кальция в моче). Определяют по степени мутности жидкости. Проба Рерберга (определяют параллельно креатинин в моче и в венозной крови, затем производят перерасчет в зависимости от веса и возраста). Назначают при гломерулонефритах, почечной недостаточности.
- Биохимический анализ мочи включает в себя определение амилазы, мочевой кислоты, креатинина, глюкозы, белка, мочевины, ионов, кальция и магния.
Вывод
Судя по показателям и видам исследования можно сказать, что исследования мочи не теряет свою актуальность с годами. Исследования весьма информативны, экономичны, эффективны. Подготовка и сбор материала не составляет большого труда, плюс полученные результаты помогут лечащему врачу оценить клиническую картину в полной мере, соответственно поставить правильный диагноз и назначить адекватное лечение.